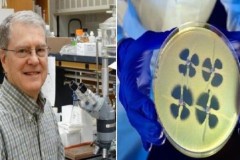
Phát hiện giải pháp tiêu diệt siêu vi khuẩn kháng các loại thuốc kháng sinh

Như các bạn đã biết, hiện nay tình trạng vi khuẩn kháng kháng sinh ngày càng bùng phát mạnh mẽ, nếu nhưng chúng ta không thể tìm ra biện pháp ngăn chặn tình trạng này thì ngày cả một bệnh viêm nhiễm nhẹ cũng có thể khiến ta tử vong nhanh chóng. Vì đã hơn 30 năm qua, con người chưa tìm ra được một loại khoáng sinh mới nào cả. Nhưng kháng sinh là gì thì không phải ai cũng hiểu.
Thuốc kháng sinh là gì?
Thuốc kháng sinh là những hợp chất hóa học – không kể nguồn gốc – có tác động chuyên biệt trên một giai đoạn chuyển hoá thiết yếu của vi sinh vật. Với liều điều trị, kháng sinh có thể kìm hãm hoặc tiêu diệt các vi sinh vật gây bệnh.
Thuốc kháng sinh được Alexander Fleming tìm ra.
Ai tìm ra thuốc kháng sinh?
Năm 1928, Alexander Fleming một nhà khoa học đến từ Scottland, đang loay hoay thí nghiệm với virus cúm. Khi lục lọi mớ đĩa thí nghiệm đầy các loại vi khuẩn khác nhau ông phát hiện ra một điều kỳ lạ.
Một loại nấm mốc bám vào một trong những chiếc đĩa thí nghiệm dường như đang tiêu diệt đám vi khuẩn mà nó chạm tới. Hoặc theo cách giải nghĩa hiện đại, loài nấm mốc ấy chứa những đặc tính kháng sinh.
Sau hàng năm trời truy tìm phương thuốc 'kỳ diệu', Fleming tự nhiên tìm thấy nó trong hoàn cảnh tình cờ nhất có thể.
Chỉ vài tuần sau, giáo sư đã phân loại được nấm mốc và phát hiện nó thuộc chủng Penicillium. Ông đặt tên cho thành phần có khả năng diệt khuẩn là 'Penicillin'. Và từ đó thuốc kháng sinh đầu tiên trên thế giới ra đời.
Phân loại thuốc kháng sinh
Mỗi loại thuốc kháng sinh (thuốc trụ sinh) chỉ có tác dụng với một loại vi khuẩn nhất định. Trong việc lựa chọn thuốc kháng sinh để chữa trị cho người bị nhiễm trùng, các bác sĩ sẽ tự đoán loại vi khuẩn gây bệnh. Ví dụ một số bệnh nhiễm trùng chỉ do một số loại vi khuẩn gây ra. Nếu như một loại thuốc kháng sinh được dự đoán là có tác dụng chống lại tất cả các loại vi khuẩn, thì không cần thiết phải xét nghiệm thêm nữa.
Nếu tình trạng nhiễm trùng có thể do nhiều loại vi khuẩn khác nhau hoặc một loại vi khuẩn gây ra mà được dự đoán là không bị ảnh hưởng bởi thuốc kháng sinh, thì xét nghiệm sẽ được yêu cầu thực hiện để xác định các loại vi khuẩn gây ra tình trạng nhiễm trùng từ mẫu máu, nước tiểu, hay mô từ bệnh nhân đó. Các loại vi khuẩn gây bệnh nhiễm trùng này sau đó được thử nghiệm tính nhạy cảm với các loại thuốc kháng sinh khác nhau.
Kết quả của các xét nghiệm thường mất một đến hai ngày và do đó không thể chỉ dẫn sự lựa chọn ban đầu về sử dụng thuốc kháng sinh.
Mỗi loại thuốc kháng sinh (thuốc trụ sinh) có hiệu quả trong phòng thí nghiệm thì không nhất thiết có tác dụng với người nhiễm bệnh. Hiệu quả của việc điều trị phụ thuộc vào mức độ thuốc được hấp thụ vào máu, số lượng thuốc đưa đến nơi bị nhiễm trùng và tốc độ cơ thể bài tiết thuốc. Các yếu tố này khác nhau ở từng người, tùy thuộc loại thuốc khác nhau đang dùng, sự hiện diện của một rối loạn khác và độ tuổi của người đó.
Trong việc lựa chọn thuốc kháng sinh (thuốc trụ sinh) các bác sĩ cũng xét đến tính chất và mức độ nguy hiểm của tình trạng nhiễm trùng, khả năng gây ra các tác dụng phụ, khả năng gây dị ứng và các phản ứng nghiêm trọng của thuốc và giá cả thuốc.
Sự kết hợp các loại thuốc kháng sinh (thuốc trụ sinh) đôi khi cần thiết để điều trị các trường hợp sau:
Đối với những bệnh nhiễm trùng nghiêm trọng, đặc biệt trong suốt những ngày đầu khi mà ảnh hưởng của thuốc kháng sinh đối với vi khuẩn đều chưa biết rõ.
Một số tình trạng nhiễm trùng do vi khuẩn gây ra mà phát triển một cách nhanh chóng tính năng đề kháng một loại kháng sinh đơn lẻ.
Các bệnh nhiễm trùng do nhiều loại vi khuẩn gây ra nếu như mỗi loại vi khuẩn bị ảnh hưởng bởi một loại kháng sinh khác nhau.












Cập nhật: 30/09/2016
Theo lqtthamkhaoyhoc